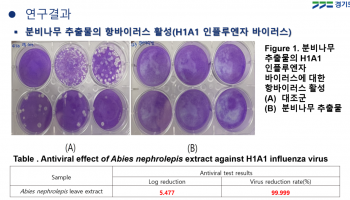
thumbimg

바이오
- '위고비' 복용한 환자, 오젬픽 복용 환자보다 '실명 위험 5배'
- 2026-03-11 [김나윤]
- 독도 흙에서 뇌질환 치료 미생물 '독도티오신' 발견
- 2026-03-09 [김나윤]
- AI가 찾은 신규물질, 항생제 내성 살모넬라 치료효과 확인
- 2026-02-19 [김나윤]
- '코로나 바이러스' 막아주는 식물 추출물 찾았다
- 2026-02-09 [김나윤]
- 토종 '광대싸리' 항암성분 생성비밀 70년만에 풀렸다
- 2026-02-06 [조인준]
- HLB, 간암 신약 FDA 본심사 돌입…7월 내 허가여부 결정
- 2026-01-29 [김나윤]
- 지방 형성 막는 '스위치' 찾았다...비만 문제 해결되려나?
- 2026-01-25 [김나윤]
- 뿌리면 1초만에 피가 '뚝'...국내 연구진 '파우더 지혈제' 개발
- 2025-12-29 [조인준]
- 셀트리온, 다중항체 신약 'CT-P72' 美 FDA 1상 IND 승인
- 2025-12-29 [김나윤]
- 셀트리온제약 'ESG위원회' 신설..."위원 전원 사외이사로 구성"
- 2025-12-11 [김나윤]
- 삼성바이오, CDP평가 수자원관리 'A등급'...최고등급 최초 획득
- 2025-12-11 [김나윤]
- 셀트리온, ADC 항암신약 'CT-P70' 美 FDA 패스트트랙 지정
- 2025-12-04 [김나윤]